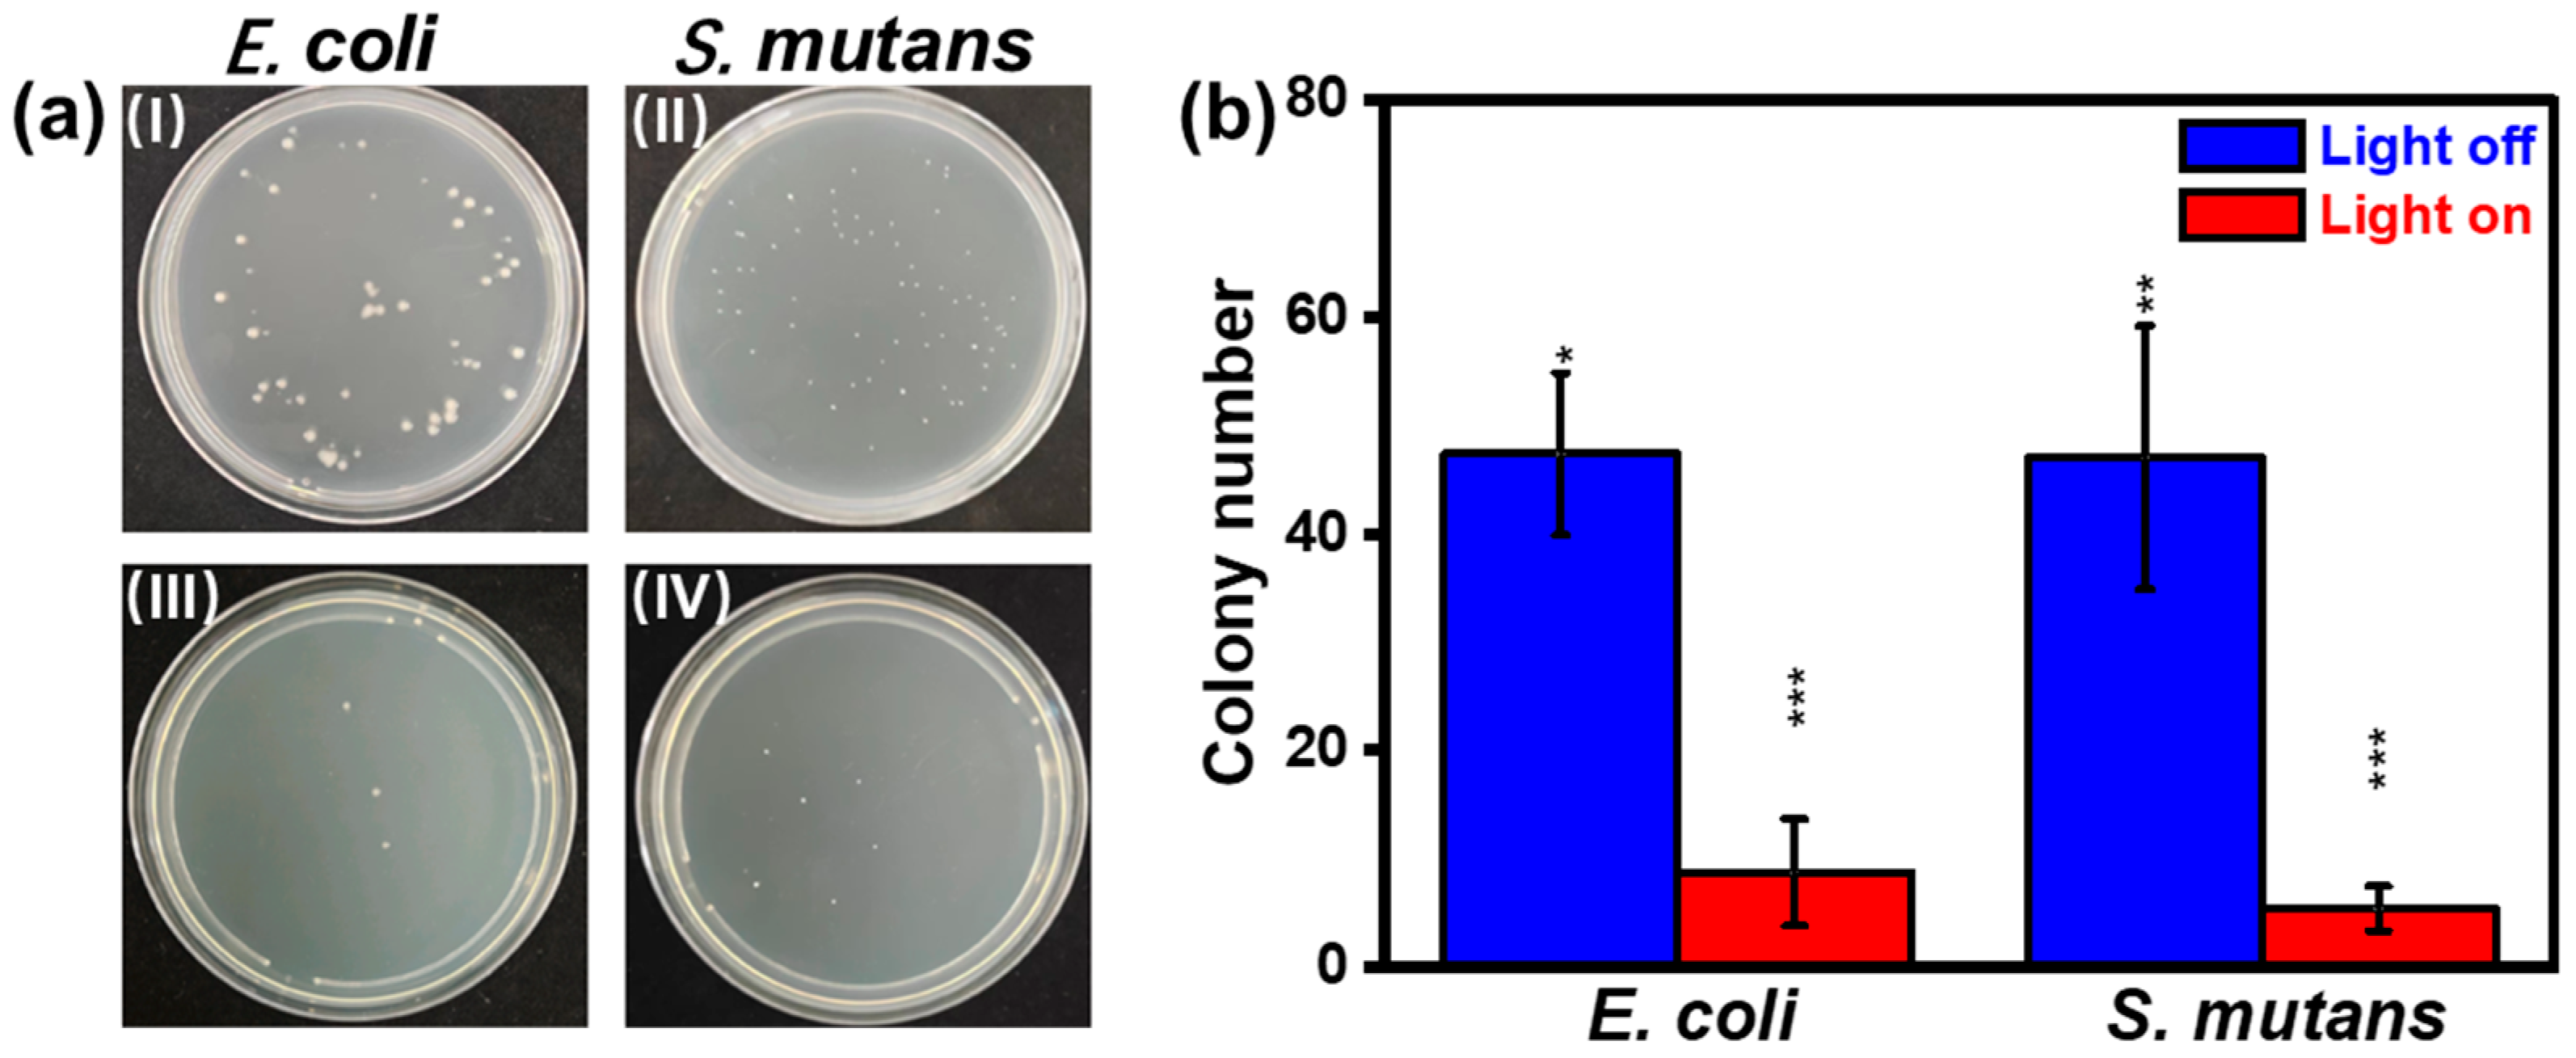
Nanomaterials 13 02381 g006

Construction of Reinforced Self-Cleaning and Efficient Photothermal PDMS@GDY@Cu Sponges toward Anticorrosion and Antibacterial Applications
Abstract
:1. Introduction
2. Materials and Methods
2.1. Materials
2.2. Synthesis of GDY@Cu
2.3. Fabrication of PDMS@GDY@Cu
2.4. Characterization
3. Results and Discussion
4. Conclusions
Supplementary Materials
Author Contributions
Funding
Data Availability Statement
Conflicts of Interest
References
- Peng, J.; Chen, B.; Wang, Z.; Guo, J.; Wu, B.; Hao, S.; Zhang, Q.; Gu, L.; Zhou, Q.; Liu, Z.; et al. Surface Coordination Layer Passivates Oxidation of Copper. Nature 2020, 586, 390–394. [Google Scholar] [PubMed]
- Daubert, J.S.; Hill, G.T.; Gotsch, H.N.; Gremaud, A.P.; Ovental, J.S.; Williams, P.S.; Oldham, C.J.; Parsons, G.N. Corrosion Protection of Copper Using Al2O3, TiO2, ZnO, HfO2, and ZrO2 Atomic Layer Deposition. ACS Appl. Mater. Interfaces 2017, 9, 4192–4201. [Google Scholar] [CrossRef] [PubMed]
- Lau, K.H.; Sanjurjo, A.; Wood, B.J. Aluminum and Alumina Coatings on Copper by Chemical Vapor Deposition in Fluidized Bed Reactors. Surf. Coat. Technol. 1992, 54–55, 234–240. [Google Scholar] [CrossRef]
- Sanjurjo, A.; Wood, B.J.; Lau, K.H.; Tong, G.T.; Choi, D.K.; McKubre, M.C.H.; Song, H.K.; Church, N. Titanium-Based Coatings on Copper by Chemical Vapor Deposition in Fluidized Bed Reactors. Surf. Coat. Technol. 1991, 49, 110–115. [Google Scholar] [CrossRef]
- Brusic, V.; Frisch, M.A.; Eldridge, B.N.; Novak, F.P.; Kaufman, F.B.; Rush, B.M.; Frankel, G.S. Copper Corrosion with and without Inhibitors. J. Electrochem. Soc. 2019, 138, 2253–2259. [Google Scholar] [CrossRef]
- Tallman, D.E.; Spinks, G.; Dominis, A.; Wallace, G.G. Electroactive Conducting Polymers for Corrosion Control. J. Solid State Electrochem. 2002, 6, 73–84. [Google Scholar] [CrossRef]
- Lin, Y.; Yasuda, H. Effect of Plasma Polymer Deposition Methods on Copper Corrosion Protection. J. Appl. Polym. Sci. 1996, 60, 543–555. [Google Scholar] [CrossRef]
- Yamamoto, Y.; Nishihara, H.; Aramaki, K. Self-Assembled Layers of Alkanethiols on Copper for Protection against Corrosion. J. Electrochem. Soc. 2019, 140, 436–443. [Google Scholar] [CrossRef]
- Patil, S.; Sainkar, S.R.; Patil, P.P. Poly(o-anisidine) Coatings on Copper: Synthesis, Characterization and Evaluation of Corrosion Protection Performance. Appl. Surf. Sci. 2004, 225, 204–216. [Google Scholar]
- Jouyandeh, M.; Tikhani, F.; Hampp, N.; Akbarzadeh Yazdi, D.; Zarrintaj, P.; Reza Ganjali, M.; Reza Saeb, M. Highly Curable Self-Healing Vitrimer-like Cellulose-Modified Halloysite Nanotube/Epoxy Nanocomposite Coatings. Chem. Eng. J. 2020, 396, 125196. [Google Scholar]
- Zhu, Z.; Zhou, F.; Zhan, S. Enhanced Antifouling Property of Fluorocarbon Resin Coating (PEVE) by the Modification of g-C3N4/Ag2WO4 Composite Step-Scheme Photocatalyst. Appl. Surf. Sci. 2020, 506, 144934. [Google Scholar] [CrossRef]
- Liu, C.; Ma, C.; Xie, Q.; Zhang, G. Self-Repairing Silicone Coatings for Marine Anti-Biofouling. J. Mater. Chem. A 2017, 5, 15855–15861. [Google Scholar] [CrossRef]
- Zhao, Y.; Zhang, J.; Xu, Q.; Mi, H.-Y.; Zhang, Y.; Li, T.; Sun, H.; Han, J.; Liu, C.; Shen, C. Ultrastable and Durable Silicone Coating on Polycarbonate Surface Realized by Nanoscale Interfacial Engineering. ACS Appl. Mater. Interfaces 2020, 12, 13296–13304. [Google Scholar] [CrossRef]
- Khatoon, H.; Ahmad, S. Vanadium Pentoxide-Enwrapped Polydiphenylamine/Polyurethane Nanocomposite: High-Performance Anticorrosive Coating. ACS Appl. Mater. Interfaces 2019, 11, 2374–2385. [Google Scholar] [CrossRef]
- Zhang, Y.; Huang, P.; Guo, J.; Shi, R.; Huang, W.; Shi, Z.; Wu, L.; Zhang, F.; Gao, L.; Li, C.; et al. Graphdiyne-Based Flexible Photodetectors with High Responsivity and Detectivity. Adv. Mater. 2020, 32, 2001082. [Google Scholar] [CrossRef]
- Wu, L.; Dong, Y.; Zhao, J.; Ma, D.; Huang, W.; Zhang, Y.; Wang, Y.; Jiang, X.; Xiang, Y.; Li, J.; et al. Kerr Nonlinearity in 2D Graphdiyne for Passive Photonic Diodes. Adv. Mater. 2019, 31, 1807981. [Google Scholar] [CrossRef]
- Du, Y.; Zhou, W.; Gao, J.; Pan, X.; Li, Y. Fundament and Application of Graphdiyne in Electrochemical Energy. Acc. Chem. Res. 2020, 53, 459–469. [Google Scholar] [CrossRef] [PubMed]
- Li, B.; Lai, C.; Zhang, M.; Zeng, G.; Liu, S.; Huang, D.; Qin, L.; Liu, X.; Yi, H.; Xu, F.; et al. Graphdiyne: A Rising Star of Electrocatalyst Support for Energy Conversion. Adv. Energy Mater. 2020, 10, 2000177. [Google Scholar] [CrossRef]
- Liu, J.; Chen, C.; Zhao, Y. Progress and Prospects of Graphdiyne-Based Materials in Biomedical Applications. Adv. Mater. 2019, 31, 1804386. [Google Scholar] [CrossRef]
- Zhao, Y.; Tang, H.; Yang, N.; Wang, D. Graphdiyne: Recent Achievements in Photo- and Electrochemical Conversion. Adv. Sci. 2018, 5, 1800959. [Google Scholar] [CrossRef]
- Gao, Y.; Xue, Y.; Liu, T.; Liu, Y.; Zhang, C.; Xing, C.; He, F.; Li, Y. Bimetallic Mixed Clusters Highly Loaded on Porous 2D Graphdiyne for Hydrogen Energy Conversion. Adv. Sci. 2021, 8, 2102777. [Google Scholar] [CrossRef]
- Lv, Q.; Wang, N.; Si, W.; Hou, Z.; Li, X.; Wang, X.; Zhao, F.; Yang, Z.; Zhang, Y.; Huang, C. Pyridinic Nitrogen Exclusively Doped Carbon Materials as Efficient Oxygen Reduction Electrocatalysts for Zn-Air Batteries. Appl. Catal. B Environ. 2020, 261, 118234. [Google Scholar] [CrossRef]
- Xu, F.; Meng, K.; Zhu, B.; Liu, H.; Xu, J.; Yu, J. Graphdiyne: A New Photocatalytic CO2 Reduction Cocatalyst. Adv. Funct. Mater. 2019, 29, 1904256. [Google Scholar] [CrossRef]
- Zou, H.; Rong, W.; Long, B.; Ji, Y.; Duan, L. Corrosion-Induced Cl-Doped Ultrathin Graphdiyne toward Electrocatalytic Nitrogen Reduction at Ambient Conditions. ACS Catal. 2019, 9, 10649–10655. [Google Scholar] [CrossRef]
- Zhang, S.; Si, H.; Fan, W.; Shi, M.; Li, M.; Xu, C.; Zhang, Z.; Liao, Q.; Sattar, A.; Kang, Z.; et al. Graphdiyne: Bridging SnO2 and Perovskite in Planar Solar Cells. Angew. Chem. Int. Ed. 2020, 59, 11573–11582. [Google Scholar] [CrossRef]
- An, J.; Zhang, H.; Qi, L.; Li, G.; Li, Y. Self-Expanding Ion-Transport Channels on Anodes for Fast-Charging Lithium-Ion Batteries. Angew. Chem. Int. Ed. 2022, 61, e202113313. [Google Scholar]
- Hu, Y.; Wang, M.; Hu, L.; Hu, Y.; Guo, J.; Xie, Z.; Wei, S.; Wang, Y.; Zi, Y.; Zhang, H.; et al. Recent Advances in Two-Dimensional Graphdiyne for Nanophotonic Applications. Chem. Eng. J. 2022, 450, 138228. [Google Scholar] [CrossRef]
- Zhu, Z.; Bai, Q.; Li, S.; Li, S.; Liu, M.; Du, F.; Sui, N.; Yu, W.W. Antibacterial Activity of Graphdiyne and Graphdiyne Oxide. Small 2020, 16, 2001440. [Google Scholar] [CrossRef] [PubMed]
- Wang, R.; Shi, M.; Xu, F.; Qiu, Y.; Zhang, P.; Shen, K.; Zhao, Q.; Yu, J.; Zhang, Y. Graphdiyne-Modified TiO2 Nanofibers with Osteoinductive and Enhanced Photocatalytic Antibacterial Activities to Prevent Implant Infection. Nat. Commun. 2020, 11, 4465. [Google Scholar] [CrossRef]
- Zhang, Y.; Liu, W.; Li, Y.; Yang, Y.W.; Dong, A.; Li, Y. 2D Graphdiyne Oxide Serves as a Superior New Generation of Antibacterial Agents. iScience 2019, 19, 662–675. [Google Scholar] [CrossRef]
- Gao, X.; Zhou, J.; Du, R.; Xie, Z.; Deng, S.; Liu, R.; Liu, Z.; Zhang, J. Robust Superhydrophobic Foam: A Graphdiyne-Based Hierarchical Architecture for Oil/Water Separation. Adv. Mater. 2016, 28, 168–173. [Google Scholar] [CrossRef] [PubMed]
- Min, H.; Qi, Y.; Zhang, Y.; Han, X.; Cheng, K.; Liu, Y.; Liu, H.; Hu, J.; Nie, G.; Li, Y. A Graphdiyne Oxide-Based Iron Sponge with Photothermally Enhanced Tumor-Specific Fenton Chemistry. Adv. Mater. 2020, 32, 2000038. [Google Scholar] [CrossRef] [PubMed]
- Li, S.; Chen, Y.; Liu, H.; Wang, Y.; Liu, L.; Lv, F.; Li, Y.; Wang, S. Graphdiyne Materials as Nanotransducer for In Vivo Photoacoustic Imaging and Photothermal Therapy of Tumor. Chem. Mater. 2017, 29, 6087–6094. [Google Scholar] [CrossRef]
- Shang, H.; Zuo, Z.; Li, L.; Wang, F.; Liu, H.; Li, Y.; Li, Y. Ultrathin Graphdiyne Nanosheets Grown in situ on Copper Nanowires and Their Performance as Lithium-Ion Battery Anodes. Angew. Chem. Int. Ed. 2018, 57, 774–778. [Google Scholar] [CrossRef]
- Li, G.; Li, Y.; Liu, H.; Guo, Y.; Li, Y.; Zhu, D. Architecture of Graphdiyne Nanoscale Films. Chem. Commun. 2010, 46, 3256–3258. [Google Scholar] [CrossRef]
- Yan, H.; Yu, P.; Han, G.; Zhang, Q.; Gu, L.; Yi, Y.; Liu, H.; Li, Y.; Mao, L. High-Yield and Damage-free Exfoliation of Layered Graphdiyne in Aqueous Phase. Angew. Chem. Int. Ed. 2019, 58, 746–750. [Google Scholar] [CrossRef] [PubMed]
- Zhao, F.; Wang, N.; Zhang, M.; Sapi, A.; Yu, J.; Li, X.; Cui, W.; Yang, Z.; Huang, C. In situ Growth of Graphdiyne on Arbitrary Substrates with a Controlled-Release Method. Chem. Commun. 2018, 54, 6004–6007. [Google Scholar] [CrossRef]
- Zhou, J.; Gao, X.; Liu, R.; Xie, Z.; Yang, J.; Zhang, S.; Zhang, G.; Liu, H.; Li, Y.; Zhang, J.; et al. Synthesis of Graphdiyne Nanowalls Using Acetylenic Coupling Reaction. J. Am. Chem. Soc. 2015, 137, 7596–7599. [Google Scholar] [CrossRef]
- Bae, S.; Kim, H.; Lee, Y.; Xu, X.; Park, J.-S.; Zheng, Y.; Balakrishnan, J.; Lei, T.; Kim, H.R.; Song, Y.I.; et al. Roll-to-Roll Production of 30-Inch Graphene Films for Transparent Electrodes. Nat. Nanotechnol. 2010, 5, 574–578. [Google Scholar] [CrossRef]
- Tsuji, Y.; Yoshizawa, K. Competition between Hydrogen Bonding and Dispersion Force in Water Adsorption and Epoxy Adhesion to Boron Nitride: From the Flat to the Curved. Langmuir 2021, 37, 11351–11364. [Google Scholar] [CrossRef]
- Wang, M.; Zi, Y.; Zhu, J.; Huang, W.; Zhang, Z.; Zhang, H. Construction of Super-Hydrophobic PDMS@MOF@Cu Mesh for Reduced Drag, Anti-Fouling and Self-Cleaning towards Marine Vehicle Applications. Chem. Eng. J. 2021, 417, 129265. [Google Scholar] [CrossRef]
- Hu, Y.; Xu, Z.; Hu, Y.; Hu, L.; Zi, Y.; Wang, M.; Feng, X.; Huang, W. Bismuth Quantum Dot (Bi QD)/Polydimethylsiloxane (PDMS) Nanocomposites with Self-Cleaning and Antibacterial Activity for Dental Applications. Nanomaterials 2022, 12, 3911. [Google Scholar] [CrossRef] [PubMed]
- Wang, M.; Zhang, Z.; Li, Y.; Men, X. An Eco-Friendly One-Step Method to Fabricate Superhydrophobic Nanoparticles with Hierarchical Architectures. Chem. Eng. J. 2017, 327, 530–538. [Google Scholar] [CrossRef]
- Long, M.; Tang, L.; Wang, D.; Li, Y.; Shuai, Z. Electronic Structure and Carrier Mobility in Graphdiyne Sheet and Nanoribbons: Theoretical Predictions. ACS Nano 2011, 5, 2593–2600. [Google Scholar] [CrossRef]
- Bi, X.; Bai, Q.; Wang, L.; Du, F.; Liu, M.; Yu, W.W.; Li, S.; Li, J.; Zhu, Z.; Sui, N.; et al. Boron Doped Graphdiyne: A Metal-Free Peroxidase Mimetic Nanozyme for Antibacterial Application. Nano Res. 2022, 15, 1446–1454. [Google Scholar] [CrossRef]
- Xin, Q.; Shah, H.; Nawaz, A.; Xie, W.; Akram, M.Z.; Batool, A.; Tian, L.; Jan, S.U.; Boddula, R.; Guo, B.; et al. Antibacterial Carbon-Based Nanomaterials. Adv. Mater. 2019, 31, 1804838. [Google Scholar] [CrossRef]

Disclaimer/Publisher’s Note: The statements, opinions and data contained in all publications are solely those of the individual author(s) and contributor(s) and not of MDPI and/or the editor(s). MDPI and/or the editor(s) disclaim responsibility for any injury to people or property resulting from any ideas, methods, instructions or products referred to in the content. |
© 2023 by the authors. Licensee MDPI, Basel, Switzerland. This article is an open access article distributed under the terms and conditions of the Creative Commons Attribution (CC BY) license (https://creativecommons.org/licenses/by/4.0/).
Share and Cite
Hu, Y.; Pu, J.; Hu, Y.; Zi, Y.; Chen, H.; Wang, M.; Huang, W. Construction of Reinforced Self-Cleaning and Efficient Photothermal PDMS@GDY@Cu Sponges toward Anticorrosion and Antibacterial Applications. Nanomaterials 2023, 13, 2381. https://doi.org/10.3390/nano13162381
Hu Y, Pu J, Hu Y, Zi Y, Chen H, Wang M, Huang W. Construction of Reinforced Self-Cleaning and Efficient Photothermal PDMS@GDY@Cu Sponges toward Anticorrosion and Antibacterial Applications. Nanomaterials. 2023; 13(16):2381. https://doi.org/10.3390/nano13162381
Chicago/Turabian StyleHu, Yi, Junmei Pu, Yingzi Hu, You Zi, Hongyan Chen, Mengke Wang, and Weichun Huang. 2023. "Construction of Reinforced Self-Cleaning and Efficient Photothermal PDMS@GDY@Cu Sponges toward Anticorrosion and Antibacterial Applications" Nanomaterials 13, no. 16: 2381. https://doi.org/10.3390/nano13162381
APA StyleHu, Y., Pu, J., Hu, Y., Zi, Y., Chen, H., Wang, M., & Huang, W. (2023). Construction of Reinforced Self-Cleaning and Efficient Photothermal PDMS@GDY@Cu Sponges toward Anticorrosion and Antibacterial Applications. Nanomaterials, 13(16), 2381. https://doi.org/10.3390/nano13162381

